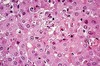
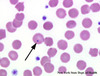
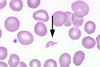

Introductory Veterinary Pathology Flashcards
(121 cards)
Describe cellular dysplasia.
Alteration in the size, shape or organization of a tissue
What is aplasia?
Organ does not develop at all and only rudimentary tissue is present
What is agenesis?
Failure of any development due to lack of embryonic primordial tissue
Describe hydropic degeneration.
- Cellular injury
- Reversible
- Often results from hypoxia as reduced ATP levels cause cell to switch to anaerobic metabolism causing depletion of glycogen and accumulation of lactate and inorganic phosophates which inhibits membrane sodium/potassium pump and water moves into the cell
- Characterized by cytoplasmic swelling and extensive vaculolation which does not histopathologically stain for fat (Oil Red O) or glycogen (Periodic Acid-Schiff Stain)
- Can progress to ‘Ballooning Degeneration’
What is oncotic necrosis?
Swelling of cell due to excessive water entry (hydropic degeneration) and subsequent cellular death
Describe coagulative necrosis.
- Cell death typically caused by ischemia or infarction.
- The architecture of dead cells is preserved for at least a couple of days.
Describe caseous necrosis.
- Form of cell death in which the tissue maintains a cheese-like appearance. The dead tissue appears as a soft and white proteinaceous dead cell mass.
- Evidence of chronic lesion
- May develop dystrophic calcification
- On microscopic examination with H&E staining, it is characterized by acellular pink areas of necrosis surrounded by a granulomatous inflammatory process.
Decribe gangrenous necrosis.
- Type of necrosis caused by a critically insufficient blood supply
- Grossly, tissues appear black in colour
What is dystrophic calcification?
- Calcification occurring in degenerated or necrotic tissue
- It occurs in areas of cell necrosis in which activated phosphatases bind calcium ions to phospholipids in the membrane.
What is Karyorrhexis?
The breaking of nuclei into pieces.
What is pyknosis?
The apparent shrinking of the cellular nucleus upon microscopic investigation
Describe lipidosis.
- Intracellular (intracytoplasmic) accumulations of fat. The liver is susceptible because of its central role in lipid metabolism
- Mechanisms
- Excessive free fatty acids from diet or adipose tissue breakdown
- Toxic damage affecting metabolism of fatty acids and triglycerides
What is fatty infiltration?
- Replacement of cells by adipocytes
- Can occurs because of old age or obesity
What is hameosiderin?
Iron storage complex found in red blood cells
What is an empyema?
- the collection of suppurative/ purlent inflammatiory fluid (pus) in a cavity in the body
- Dominated by neutrophils, both dead and alive
- Contains dead host cells
- Often caused by bacteria
- May become walled off by granulation or fibrous tissue causing an abcess
How does fibrinous inflammation occur?
- Forms as a result of increased vascular permeability and fibrinogen escape from the vascular system which polymerizes to fibrin by thrombin
- Acute phenomenon
Describe mucus/catarrhal inflammation.
- Caused by mucus hypersecretion which accompanies inflammation
- Often found in respiratory and gastrointestinal tracts where mucus-secreting cells are prominent
Describe this gross pathology.

Caseous necrosis in the pleura
What cell is this?

Eosinophil of a horse
Describe the prominent process occuring

Erythrophagocytosis
Describe the process occuring

Fatty infiltration of the muscle fascicle
Describe the gross pathology

- Fibrinous inflammation
- Acute phenomenon which occurs as a result of increased vascular permeability and fibrinogen escape from the vascular system which polymerizes to fibrin by thrombin
What cell type is pictured here?

Fibroblasts
Describe this process

Fibrosis of the liver